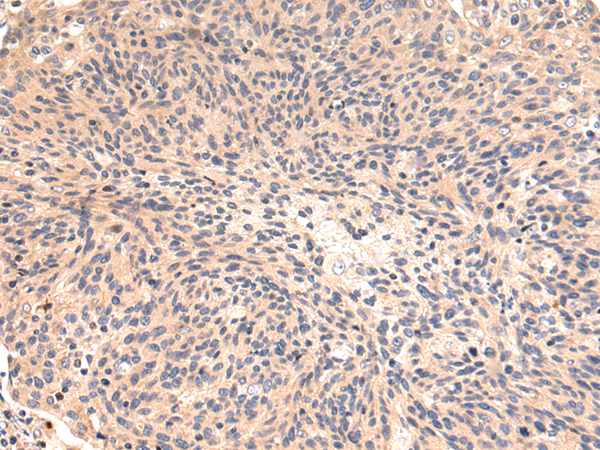

-
分类: 科研抗体货号: P08400别名: KMT7; SET7; SET9; SET7/9应用: IHC反应种属: Human, Mouse
-
分类: 科研抗体货号: P08401别名: HL应用: WB,IHC反应种属: Human, Mouse, Rat
-
分类: 科研抗体货号: P08418别名: I; HSD3B; HSDB3; HSDB3A; SDR11E1; 3BETAHSD应用: WB,IHC反应种属: Human
-
分类: 科研抗体货号: P08399别名: MG44; KMT1A; SUV39H; H3-K9-HMTase 1应用: WB反应种属: Human, Mouse
-
分类: 科研抗体货号: P08417别名: C11; CDR; DD4; CHDR; DD-4; HAKRA; 3-alpha-HSD应用: WB,IHC反应种属: Human
-
分类: 科研抗体货号: P08397别名: H2AH; H2A/S; H2AFALii; HIST1H2AH; dJ86C11.1应用: WB,IHC反应种属: Human, Mouse
-
分类: 科研抗体货号: P08416别名: SCDR9; NIIL497; SDR16C3; HMFN0376应用: WB,IHC反应种属: Human, Rat
-
分类: 科研抗体货号: P08396别名: HIF1; MOP1; PASD8; HIF-1A; bHLHe78; HIF-1alpha; HIF1-ALPHA; HIF-1-alpha应用: WB,IHC反应种属: Human, Mouse
-
分类: 科研抗体货号: P08413别名: DBP; MFE-2; MPF-2; PRLTS1; SDR8C1应用: WB,IHC反应种属: Human, Mouse, Rat
-
分类: 科研抗体货号: P08395别名: TMPRSS1应用: IHC反应种属: Human, Mouse, Rat

鄂公网安备42018502007531号
鄂公网安备42018502007531号

